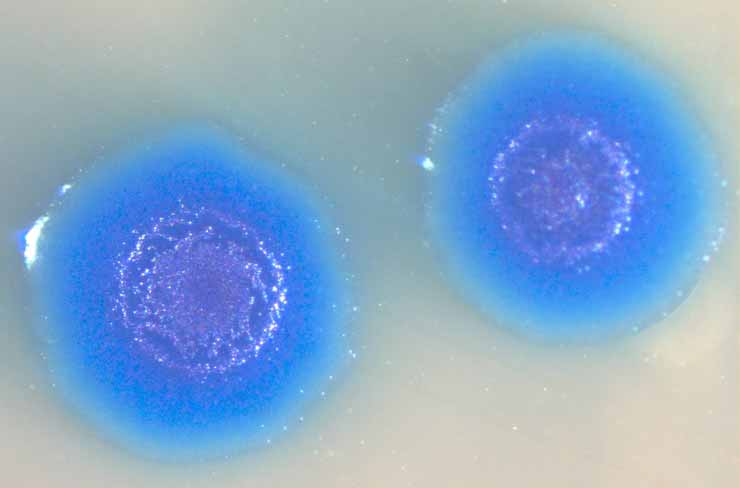
Игра в бога: искусственные организмы - 5

Что-то вроде тизера. Ксеноморфы существуют. Учёные создают ксеноморфов. Учёные создают ксеноморфов из соображений безопасности. Я сам в шоке. Под катом подробнее об этом (а это, кстати, совершенно официально называется ксенобиология) и о много другом, чем занимаются современные биологи. Не всё ж вам про COVID-19 читать!
Это первая часть текста, написанного по мотивам эпизода подкаста про искусственные организмы.

Автор Malcolm Lightbody
Мы поговорили с Машей Шутовой из венчурного фонда 4biocapital, Инной Зухер из Оксфорда и Сергеем Нурком из National Human Genome Research Institute.
Да будет биолюминесценция
В контексте искусственных организмов светящиеся объекты – это первое, что приходит на ум дилетанту. Сразу вспоминаются светящиеся зелёные мыши или стартап, который создаёт люминесцентные комнатные растения. Любого, кто первый раз в жизни слышит про светящиеся кактусы, мышек и свиней, сразу начинает мучать вопрос: «Зачем учёные этим занимаются?»
Один из ярких примеров пользы такого рода исследований – это красивое открытие, которое пролило свет (во всех смыслах этого слова) на обнаружение и лечение рака прямой кишки. Учёные разместили в клетках кишечника генетическую конструкцию, которая состояла из последовательно связанных друг с другом четырёх генов, светящихся разными цветами. Дальше эти гены перемешали в случайной последовательности и на выходе у нас случилось энное количество клеток, светящихся разными цветами. Потом дали им подрасти, и их «дети» унаследовали соответствующий им цвет. Получилась очень красивая картинка, которая показывает где «родители»-клетки, а где «дети»-клетки. При помощи такого метода можно показать из каких клеток рак происходит с большой вероятностью.
К слову про зелёных мышек, есть один интересный факт. Сейчас цветов, с помощью которых можно «подсвечивать» белки, стало очень много, но одни из первых – это зеленые белки из медузы. Они были выведены и запатентованы в России, так что можно их считать нашей национальной гордостью.
В 2006 году в Национальном университете Тайваня, при помощи введения гена этих белков в ДНК-цепочку эмбриона и имплантации его в матку самки свиньи, были выведены светящиеся зелёные поросята. На тот момент зелёные свиньи уже существовали, но у них наблюдалась лишь частичная флуоресценция. Животные, полученные после эксперимента под руководством профессора У Шинь-Чжи стали единственными в мире свиньями, у которых даже сердце и внутренние органы были зелёного цвета. Как и в первом случае, эти эксперименты расцениваются учёными как возможность визуального наблюдения за развитием тканей при пересадке стволовых клеток.

Светящиеся свиньи на фоне обычного поросёнка
Возможности визуально отслеживать, что происходит с клетками определённого типа, ещё активно используют исследователи, которые занимаются изучением регенерации. К примеру, учёный отпиливает плавники каким-то несчастным рыбкам, а потом наблюдает за тем, как эти плавники отрастают обратно. Для таких исследований очень активно используются флуоресцентные белки. Геном рыбки модифицируют так, чтобы светящийся белок позволял отслеживать, каким образом происходит распространение клеток определённого типа по восстановившемуся плавнику.
Ещё можно на основании этих светящихся белков делать биосенсоры: засовывать их в бактерию, и делать так, чтобы она начинала экспрессировать белок в обмен на определённый внешний раздражитель. Классный пример применения этой технологии — исследования, которые пытаются сделать биосенсор для детектирования продуктов распада взрывчатых веществ. Так, к примеру, можно обнаруживать мины, которые еще не разминировали.
Вначале было слово, и слово было из нуклеотидов
Давайте от искусственных организмов, которые мы видим невооруженным глазом, перейдём к искусственным организмам, которые невооруженным глазом заметить не удастся, но от которых пользы не меньше. К примеру, в клеточной биологии и, в частности, в клеточной терапии будущего есть отдельное направление: можно же не только замещать какие-то клетки, которых организму не хватает, но ещё и заставить эти клетки производить что-то, что нам важно и интересно, например, тот же инсулин. Сейчас в этом направлении очень много исследований, но пока что ни одно из них не идет к своему логическому завершению. Однако, идеи в духе «давайте сделаем клетки, которые будут в ответ на глюкозу выделять инсулин, и таким образом помогать людям с диабетом первого типа» звучат регулярно.
Вообще, сейчас есть целое отдельное направление исследований, связанное с созданием искусственных микроорганизмов. Есть такой человек Крейг Вентер, у него есть институт, соответственно, Крейга Вентера. Последние двадцать лет учёные в этом институте пытаются создать бактерию с минимальным набором генов. Они взяли бактерию под названием «микоплазма». Это паразитическая бактерия, у которой исходно-то не очень много генов, около тысячи. Для сравнения: у кишечной палочки почти пять тысяч. Так вот они взяли один вид микоплазмы, убрали из неё ДНК и поместили туда искусственно синтезированную хромосому другого вида микоплазмы. Тем самым показали, что из одной микоплазмы можно сделать другую. Это был их синтетический организм номер один.
Колонии того самого организма номер один
Колонии того самого организма номер один
У этого получившегося синтетического организма номер один всё ещё было как-то слишком много генов. Так что исследователи решили убрать всё лишнее. Сначала они решили, что сейчас сядут и просто прикинут, что «жизненно» необходимо, а что можно выбросить. Попытались побыть в роли разумного создателя жизни. Пробовали-пробовали, но у них ничего не получилось. Крейг Вентер был страшно удивлён, но признал, что состояние современной науки недостаточно прогрессивно, чтобы просто сесть и с нуля создать что-то живое. После этого они отказались от идеи такого «разумного» создания жизни, и пошли другим путём. Решили получить организм с минимальным набором генов перебором.
 Схема экспериментов, проводимых в институте Вентера
Схема экспериментов, проводимых в институте Вентера
Вентер со товарищи решили получить организм с минимальным набором генов перебором. Взяли эти девятьсот генов своего организма номер один, стали компоновать их небольшими пачками, засовывать в бактерии, и смотреть, без каких генов бактерии умирают. Через сколько-то операций, протестировав сотни комбинаций, они смогли создать организм, в котором было около четырёхсот генов. Это был действительно, живущий, делящийся, образующий колонии организм, в котором генов меньше, чем в любом естественном организме. Хотя тут надо понимать, что это очень простая паразитическая бактерия, свободно она не живёт.
 Искусственный организм с минимальным набором генов, способный к делению, aka организм номер три
Искусственный организм с минимальным набором генов, способный к делению, aka организм номер три
Этот получившийся минимальный организм для удобства назывался организм номер три, потому что организм номер два был какой-то промежуточной стадией. По сути, естественная среда или «природа» — это brute force mechanism, который сводится к тому, что умирающие — умирают, а выживающие — делятся и размножаются. Так что самый надёжный способ экспериментов с синтетическими организмами сейчас сводится к тому, что учёный скармливает природе что-нибудь, даёт ей разнообразие, а дальше она сама отбирает то, что работает.
Подобным образом экспериментируют не только с бактериями, но и, например, с вирусами. Есть такие аденоассоциированные вирусы, которые очень активно сейчас используются для доставки генетической терапии. В природе довольно много аденоассоциированных вирусов, но одно из свойств, которое важно для терапии, — это куда они попадают в теле человека. Есть вирусы, которые «застревают» в печени, есть такие, которые могут проходить гематоэнцефалический барьер и попадать в , а есть те, что оседают в лёгких. Это важный параметр, потому он позволяет учёным и врачам сделать терапию более направленной.
Видимое временно, а невидимое вечно
С одной стороны, само осознание того, что мы сейчас можем с лёгкостью синтезировать геном практически любого микроорганизма с нуля, должно несколько пугать. К примеру, геном возбудителя сибирской язвы, в принципе, находится в открытом доступе. При этом, учитывая что мы умеем хорошо сохранять ДНК в её первозданном виде на протяжении долгого времени, в принципе, восстанавливая последовательность, можно не очень спешить: главное заморозить достаточное количество ДНК.
С другой стороны, синтетическая биология открывает новые возможности в плане восстановления вымерших видов. К примеру, Джордж Чёрч и его группа пытается сделать нового мамонта из слона, мутируя соответствующие участки ДНК. Корейский учёный с крайне противоречивой репутацией Хван У Сок работал вместе с учёными из Якутии и пытался воссоздать мамонта напрямую из остатков ДНК. Про это даже есть документальный фильм. По всей планете есть проекты по восстановлению плейстоценовой мегафауны. Есть такой плейстоценовый парк и в России. Такие парки ждут мамонта с распростёртыми объятиями, говорят: «Дайте мамонта уже наконец!»
 Кадр из документального фильма Genesis 2.0
Кадр из документального фильма Genesis 2.0
На фоне развития возможностей современной биологии борьба за сохранение видов тоже трансформируется. Появилось целое направление (conservation biology), в котором учёные борются за то, чтобы у вымирающих видов появился генетический бэкап. Есть целый ряд проектов по секвенированию последовательности генома для видов, которые находятся на грани вымирания, и вот-вот покинут нашу планету.
По образу и подобию своему
Есть стандартный набор рибонуклеотидов и дезоксирибонуклеотидов, который кодирует всё живое, что есть в природе. Однако, совершенно не обязательно себя им ограничивать. Если учёные используют альтернативный набор нуклеотидов и создают из него искусственный организм, то эта штука никаким естественным образом получиться точно не может. Это направление исследований и называется ксенобиологией.
 Источник. «Через четыре миллиарда лет в Эдеме расцветает новое дерево ксенобиологии»
Источник. «Через четыре миллиарда лет в Эдеме расцветает новое дерево ксенобиологии»
Важно понимать, что это не просто праздный интерес. У ксенобиологии есть несколько важных и очень понятных применений. К примеру, если мы создаём такой вот странный организм, который использует другой набор нуклеотидов в своём ДНК, то этот организм, к примеру, оказывается не подвержен природными вирусам. С другой стороны, пропадает опасность, что части этих искусственных организмов каким-то образом могут попасть в другие живущие вокруг нас клетки. То есть такие «ксеноморфы» не смогут негативно повлиять на окружающую среду.
Пока что такие искусственные организмы создать не удалось, но эксперименты в этом направлении идут, и каких-то непреодолимых ограничений тут нет. В природе есть двадцать аминокислот, и каждая аминокислота кодируется набором из трёх букв. Комбинаций всего шестьдесят четыре, но все заняты, и каждая комбинация что-нибудь означает в живой клетке. Если мы добавим к этим четырём буквам ещё пару букв, то генетический код замечательным образом расширяется. Мы получаем множество новых кодонов, которые могут позволить, к примеру, добавлять в белки всякие необычные аминокислоты. Правда, чтобы добавить эти дополнительные нуклеотиды, надо не просто научить бактерию синтезировать эти нуклеотиды, и вставлять всё это в ДНК. Нужно ещё добавить машинерию синтеза белка, которая будет узнавать эти кодоны, и сделать ещё не мало других изменений. Пока учёные только начинают работать в этом направлении, но перспективы тут, кажется, ограничены только воображением исследователя.
Автор: Иван Ямщиков








